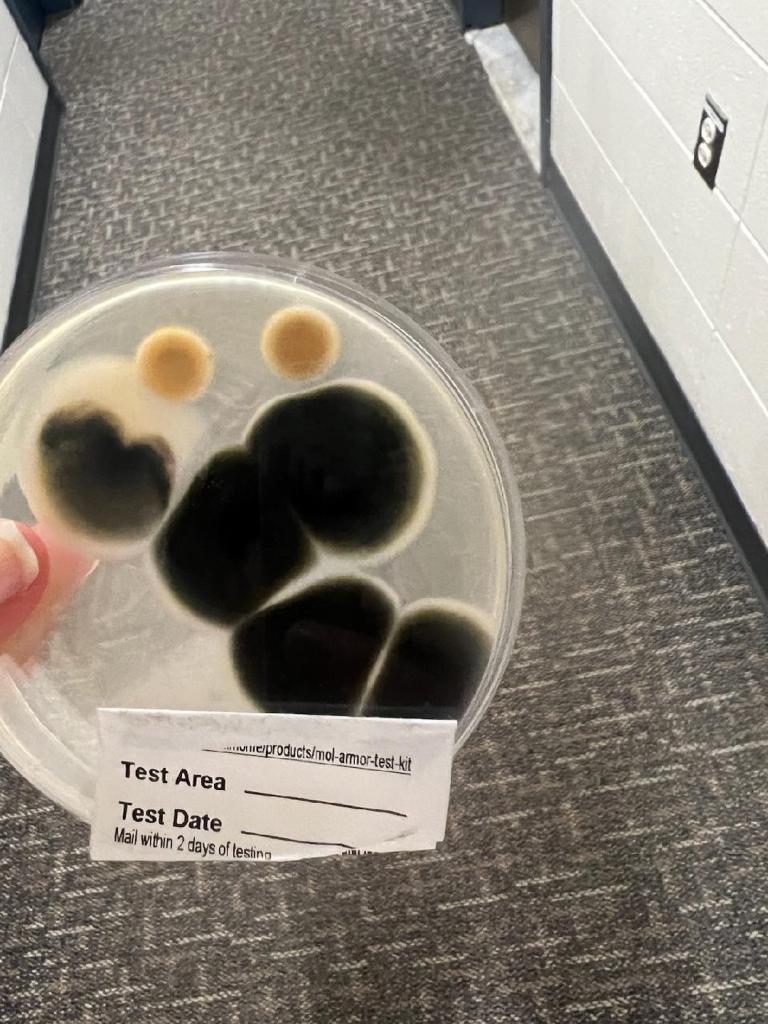
A mold sample from a UVM dorm

One by one, students took the microphone at Burlington City Hall last month to recount horror stories about living in dorms at the University of Vermont.
They told the Burlington City Council about fungi growing in damp bathrooms, perpetually leaky ceilings and infestations of silverfish, which are pesky insects that thrive in humid places. The students also submitted photographic evidence. One picture, taken at UVM’s Trinity Campus, showed a wooden dresser speckled black. “A LOT OF MOLD,” read the caption.
Unlike traditional apartments, college dormitories are exempt from routine inspections by city officials. Instead, colleges in Burlington must confirm every year that the dorms meet the city’s strict housing code. But UVM hasn’t filed the necessary paperwork for at least 15 years. Now, a group of students is calling them out.
They’ve created the UVM Student Tenant Union to pressure the university to respond to their complaints. Getting the attention of the council — and city inspectors — is one strategy.
UVM officials, meanwhile, say they address housing concerns promptly. They’ve also asked the city to back off, claiming they’re not subject to the rules.
“Students deserve housing that is of the standard of the rest of our rental housing stock.”
City Councilor Marek Broderick
The students, though, have a powerful ally in their midst: Councilor Marek Broderick (P-Ward 8), a UVM student who said he’s heard complaints about campus housing for years. Later this month, he plans to introduce a resolution asking the parties to come to the table and figure out a solution.
“Students deserve housing that is of the standard of the rest of our rental housing stock,” he said. “They are just as much residents of Burlington as anyone else.”
UVM houses more than 6,000 students in 41 residence halls. The oldest dorm, Converse Hall, was built in 1895, while the newest units, at Catamount Run in South Burlington’s Market Street neighborhood, began a phased opening for residents in 2024. Eighty more beds will open there next spring.
First-year and sophomore students are required to live on campus, but UVM regularly accepts more students than it can house. Many live in “forced triples,” or rooms that were built for two students but must accommodate three. There’s little room for older students on campus, so they find apartments elsewhere in Burlington, putting the squeeze on a tight housing market.
Some recent plans to build more dorms are either on hold or have been canceled. In 2022, UVM asked for a zoning change so it could build 400 undergraduate beds on its Trinity Campus on Colchester Avenue. Councilors worried that the university would use the new capacity to increase enrollment, so discussions stalled. The parties subsequently drafted an agreement that would require UVM to build beds for each new student enrolled, but two years later, the agreement isn’t final, and the talks are ongoing.
Last year, UVM halted plans to build a 540-bed complex near Interstate 89 in South Burlington, citing high construction costs. But it did manage to open Catamount Run in partnership with Redstone.
Meantime, the cost of student housing, frozen for several years, is set to rise. A 3 percent hike next academic year means a standard double room that now goes for $9,334 a year will cost $280 more.
Complaining about housing is part and parcel of going to college. But the students involved in the tenant union say their experiences go beyond basic gripes.
At tenant union meetings last week, students reported mice, clogged shower drains and drafty windows. Two students from different residence halls said they’d gotten mold poisoning. One of the students, who is studying public health, said he took a sample of the dark-colored phlegm he’d coughed up and put it under a microscope, revealing a colony of black mold.
First-year student Hope Sullivan ticked off problems in her dorm at Trinity Campus: an elevator out of commission; a broken window that hasn’t been replaced; a shower that didn’t function for the first two months of school; as well as “lots and lots” of spiders in the bathroom.
“Wow, you live in a shithole!” the student sitting next to her said.
The union members, who organized last fall, have used creative ways to collect evidence of shoddy maintenance. They’ve knocked on doors, created a Google form and held events, including one on Valentine’s Day that invited students to write complaints on paper hearts. This month, the union is running a Fucked Up Dorm Contest that will award $50 to the person with the least-enviable abode.
The efforts have resulted in a list of formal demands, including that UVM meet the city’s housing code; address maintenance issues within 30 days; and cap enrollment. Members of the union also want UVM to stop charging students to stay on campus over school breaks and to end its tiered housing system, which charges a premium for dorms with extra amenities such as air-conditioning. The result, the union says, is that lower-income students are often forced into triples, the least expensive housing option.
Seven Days asked to speak to several UVM officials, but none were made available for interviews. In a statement, UVM spokesperson Adam White defended the university’s response to housing complaints. Issues requiring urgent attention must be addressed within 48 hours, he said, while lower-priority ones must be fixed within two weeks. Over the past year, maintenance crews received more than 2,000 work orders and completed 94 percent of them on time, White said.
“We are constantly striving to improve the efficiency and effectiveness of our processes,” White wrote. “We have made multiple offers to the Student Tenant Union since the fall semester began to meet and continue the conversation about their concerns, and that offer stands.”
Students say they’ve met with UVM officials at least five times but that the talks are going nowhere. “They’ve made it extremely clear that they are not standing with us as a tenant union,” said Alva Yanowitz, a UVM junior. “They’re not going to meet our demands without further pressure.”
That includes calling for city action. Councilor Broderick got involved last year and started researching how dorms fit into the city’s housing code, which sets standards for fire safety, plumbing and sanitation. When he saw that universities must self-certify their compliance, he asked the city for UVM’s latest housing report. There wasn’t one on file, so Broderick asked to go back several more years. Bill Ward, the city’s director of permitting and inspections, said none have been filed since his tenure began in 2010.
Ward subsequently sent a letter to UVM to ask about its dorm inspection process. Amanda Clayton, UVM’s executive director of facilities management, responded with a two-page memo that listed the entities involved in building maintenance. She then wrote that UVM isn’t subject to the city’s rules and has no intention of following them.
“Certification of every aspect of these standards would interfere with the intended functional use of the institution and place an exceptional and undue burden on the University,” her letter says.

It’s unclear whether other UVM officials share Clayton’s view, as White, the spokesperson, didn’t address the question in his provided statement. Rather, he emphasized that UVM is “committed to [the] safety, comfort and community elements of our on-campus housing.”
Ward was on vacation and unavailable for an interview. But Kim Sturtevant, the assistant city attorney for Ward’s department, said the rules speak for themselves.
“We’re requiring annual, comprehensive inspection programs,” she said. “The request is clear.”
Broderick said he isn’t sure whether some of the maintenance issues reported by students would be considered violations of code. But he thinks the infamous forced triples likely are.
City code says a bedroom shared by three people must have at least 150 square feet of living space. Under that definition, many of the triples would be legal. But Broderick thinks that dorm rooms, which are used for more than sleeping, should be classified as “dwelling units,” which, by code, must be at least 350 square feet if there are three occupants.
A bill pending in the Vermont legislature, H.170, seeks to mandate more living space for students. Introduced by state Rep. Troy Headrick (I-Burlington), a longtime UVM employee, the proposed legislation would also limit UVM’s enrollment when the city’s rental vacancy rate is below 5 percent, as it is now. In February, H.170 was referred to the House Education Committee, which took no action.
Headrick first proposed a version of the bill in 2023, when both the city and UVM were under different leadership. Headrick said he’s hopeful that Mayor Emma Mulvaney-Stanak and UVM’s newly installed president, Marlene Tromp, will work to improve student housing without legislative intervention. Jen Monroe Zakaras, the mayor’s deputy chief of staff, said the two leaders will continue negotiations related to the Trinity Campus zoning request and on-campus housing over the next several months.
“I have nothing but confidence and faith that those two are going to manage this process differently than the past administration and the past mayor managed it,” Headrick said.
Meantime, Broderick plans to introduce a resolution later this month aimed at ensuring students are equally protected by the city’s housing code. The measure will call for UVM and city officials to meet with the council’s Ordinance Committee, which will be asked to assess whether the housing code needs to be clarified. It will also request that UVM submit more documentation of its existing inspection program.
Some students are hoping for more accountability. Floyd Campbell, a first-year student who lives in a triple, said the city should step up enforcement and make UVM self-certify its compliance. Yanowitz, a union member who says she got mold poisoning when she lived in a dorm, said UVM can’t be trusted to comply with the rules, so city officials should do the inspections themselves.
Broderick, however, recognizes that routinely inspecting dorms would be a heavy lift for city inspectors. New initiatives to enforce weatherization rules and regulations on buildings’ fossil fuel use have added more to the department’s plate.
“It’s possible that that’s what needs to be done, but I’m not pushing for that at the moment,” he said. “With a new UVM administration, I’m optimistic that if we can have those conversations in the Ordinance Committee, we can settle the matter.”
The students intend to keep the pressure on. A few showed up to Monday’s city council meeting to recount more tales of dorm life: a light fixture falling on a student’s head; a leak that’s persisted for at least a year; and a particularly colorful description of raw sewage soaking a bathroom floor.
The Fucked Up Dorm Contest, meantime, is still accepting entries.
The original print version of this article was headlined “The Dorms Aren’t All Right | UVM students are putting pressure on city and school officials to improve their living conditions”
This article appears in Nov 5-11 2025.

